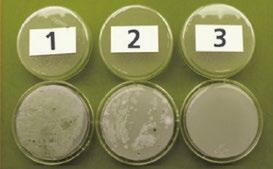

FR | 01.23
Nous sommes convaincus qu’il faut tout miser sur l’artisanat inspiré pour fabriquer le nec plus ultra en matière de bottes. C’est ce qui pousse notre entreprise familiale à s’améliorer constamment. Depuis 60 ans déjà. Chaque génération se montre plus innovante et plus perfectionniste que la précédente. Nous connaissons les défis inhérents à chaque métier : des agriculteurs qui portent des bottes Bekina pour sécuriser à la fois leur pied et leur récolte, aux pêcheurs solidement ancrés sur le pont, prêts à débarquer la pêche du jour. Dans le secteur alimentaire, nos bottes garantissent le summum du confort au travail. Même les amateurs ambitieux apprécient notre qualité professionnelle. Nous concevons les bottes optimales pour chaque professionnel, afin qu’il puisse donner le meilleur de lui-même au quotidien, en toute sécurité, en toute confiance et en tout confort. Chacun trouve ainsi chaussure à son pied et plus rien ne l’arrête !
Résolument tournés vers l’avenir, nous nous efforçons d’apporter une valeur ajoutée authentique et durable. À cet égard, nous consacrons tout notre savoir-faire belge à l’élaboration de solutions innovantes qui bénéficient à la fois aux individus et à la planète. En notre qualité de pionnier, nous avons opté dès le départ pour le polyuréthane. Ce matériau de très haute qualité garantit des bottes Bekina Boots qui tiennent jusqu’à 4 fois plus longtemps ! En plus de constituer un investissement durable pour nos clients, nos bottes permettent de réduire le transport et les déchets. Dans tous les aspects de notre organisation, nous choisissons toujours l’option la plus durable : d’une énergie 100 % verte pour la production aux initiatives qui favorisent la biodiversité aux abords de notre entreprise. C’est notre manière d’œuvrer à un monde meilleur, avec notre grande famille de clients, de collaborateurs et de partenaires.
Le travail soigné est inscrit dans les gènes de Bekina. C’est le moteur de notre soif inextinguible d’innovation et de notre recherche incessante d’une qualité durable. À la clé ? Des bottes à la qualité inégalée.

Bekina. l’artisanat au service de l’innovation.



Table des matières Neotane 4 Une botte pour chaque pied 5 Steplite Easygrip 6-7 Steplite Easyclean 8 Nettoyage 11 StepliteX Solidgrip 12-13 Biosécurité 14-17 Laboratoire 18-19 StepliteX Thermoprotec 20-21 Bottes de gréement 22-23 Semelles intérieures et assises plantaires 24 Nettoyage 25 Thermolite Iceshield 26-27 Litefield 28-29 Aperçu de produit 31
La force de Bekina Boots


QU’EST-CE QUE LA TECHNOLOGIE NEOTEANE ?
Un mélange unique de composants, qui crée une structure en mousse PU. La réaction chimique des différents composants forme un produit stratifié durable et résistant, doté de bulles d’air. À la clé :



1 des bottes très légères et flexibless
2 une excellente isolation thermique


3 une respirabilité optimale
ERGOT DE DÉCHAUSSEMENT : FACILE À DÉCHAUSSER

X4
NEOTANE
3 2 1
NEOTANE
NEOTANE
NAME OF THE SHAFT
NAME OF THE OUTSOLE
LÉGER ISOLATION THERMIQUE PLUS LONGUE DURÉE DE VIE
NEOTANE PVC PU poids isolation ans PVC PU PVC CAOUT- CHOUC CAOUT- CHOUC CAOUTCHOUC PU
Une botte pour chaque pied
LE LARGE ASSORTIMENT BEKINA NOUS PERMET DE PROPOSER UNE BOTTE CONFORTABLE ET SÛRE, ADAPTÉE AUX BESOINS ET AU TYPE DE PIED DE CHACUN :
DENIVEAUSÉCURITE
BONNE VENTILATION
Circulation optimale de l’air grâce à une tige plus large qui ne serre pas les mollets

CHAUSSANT STANDARD
PIEDS LARGES
MOLLETS LARGES
CONDITIONS FROIDES
BOTTES DE SÉCURITÉ CERTIFIÉES



sans métal sans métal
Sans embout de sécurité Avec embout de sécurité Avec embout de securité et semelle intermediare


Le modèle classique parmi les bottes agricoles, gage de confort et de durabilité.
CARACTÉRISTIQUES
• Matière souple, même à temp basse
• Chaussant standard
• excellente adhésion même sur une surface mouillée et grasse - certifiée SRC


• Résistant aux huiles et graisses, au fumier et aux produits chimiques

• Facile à nettoyer
• Poignée d’echelle dans la semelle pour plus de sécurité

+ Semelles intérieures
Bekina Boots
Pointure:
coleurs:
Normes et certificates


Je porte très souvent mes bottes Steplite EasyGrip. Il est essentiel qu’elles soient agréables à porter et ne fatiguent pas mes pieds. Le chaussant unique de Bekina Boots m’offre le confort nécessaire.

L. EU 36 - 48 | UK 3.5 - 13 | US 4 - 15 7
Julien
free
Semelle lisse:
Faciles à nettoyer et à désinfecter grâce à sa semelle lisse.
Conviennent à tous les visiteurs de la ferme et aux ouvriers pendant les épidémies (ex. grippe aviaire, peste porcine africaine, fièvre aphteuse...)
+ Semelles intérieures Bekina Boots

CARACTÉRISTIQUES
• Très légère
• Certifé SRA
• Résistant aux huiles et graisses, au fumier et aux produits chimiques
• Ergot de déchaussement: facile à déchausser
• Semelle lisse: facile à nettoyer et à désinfecter
Pointure:
couleurs:

EU 36 - 48 | UK 3.5 - 14 | US 4 - 16
free
Parfaites pour un usage intérieur.





3 2 2 1 1 3 1
Bottes sales 2 Rincées à l’eau 3 Désinfectées
Source: Départment de Agriculture et Pêche /DGZ/ University of Gent
Le confort des bottes de travail Bekina Boots est vraiment inégalé dans l’agriculture.

Nos collaborateurs portent les bottes de travail StepliteX SolidGrip avec embout en acier. Je trouve que ce sont les plus confortables parce qu’elles sont munies d’une tige large, de sorte qu’on ne ressent aucun écrasement des jambes quand on les porte sur un jean ou une salopette. En outre, elles sont très faciles à nettoyer et aucune saleté n’y adhère, ce qui n’est pas sans importance dans notre profession.
Pour un agriculteur qui travaille toute la journée à l’étable ou dans les champs, le confort est primordial. Avec les bottes de travail Bekina, je peux travailler toute la journée, voire plusieurs jours d’affilée, sans avoir mal aux pieds ni les jambes lourdes. Je n’ai jamais connu cela avec d’autres bottes.

Dominique

Vous cherchez une paire de bottes robustes pour vos tâches

agricoles quotidiennes ?

CARACTÉRISTIQUES
• Embout en acier extra haut pour une protection optimale
• Chaussant large
• Excellente adhésion même sur une surface mouillée et grasse - certifiée SRC


• Résistant aux huiles et graisses, au fumier et aux produits chimiques
• Facile à nettoyer et désinfecter
• Poignée d’echelle dans la semelle pour plus de sécurité
• Résistant aux capures
• Ergot de déchaussement: facile à déchausser
+ Bekina Boots Semelles intérieures ergonomiques





Pointure:
couleurs:
Normes et certificats :
Je porte mes bottes Bekina tous les jours et elles m’ont convaincu. Elles sont parfaitement adaptées, confortables, légères comme une plume malgré l’embout métallique et ont une adhérence exceptionnelle. J’adore mes bottes Bekina !
EU 36 - 49 | UK 3.5 - 14 | US 4 - 16
Maria Kyra
free
Utilisez des bottes dédiées par zone pour un résultat optimal en matière de biosécurité !
Nettoyage et désinfection
Achat d’animaux
Alimentation et eau
Hygiène de l’entrée
Biosécurité accrue =
Moins de maladies
Meilleur rendement
Meilleur bien-être animal
Moins d’antimicrobiens
Élimination des carcasses
Dépeuplement
Meilleures santé publique et opinion publique
Respect de la législation
Meilleure production et producti on plus saine (€€€)
BIOVEILIGHEID
Biosécurité
La mise en place d’un bon protocole d’hygiène à l’entrée de toutes les zones de l’exploitation est la mesure la plus négligée et oubliée, alors qu’il s’agit probablement du moyen le plus rapide, le plus simple et le moins cher de prévenir la prolifération des bactéries. Lavez-vous les mains, désinfectez-les et portez des bottes dédiées par zone. Chaque petit effort peut faire une grande différence à tous les niveaux de votre exploitation.
Coup d’œil sur les deux principaux objectifs de la biosécurité :
1 Prévention de nouvelles maladies ;
2 Contrôle des maladies existantes.
Dans le cadre de ces deux objectifs, nous voulons évaluer le risque et implémenter des mesures visant à le réduire et à préserver et améliorer le statut sanitaire de l’exploitation agricole. Un programme de biosécurité est (devrait être) la base de tout programme de lutte contre les maladies et devrait être pratique, rentable et révisé régulièrement.
Externe: réduire l’introduction de maladies
Interne: réduire la propagation de maladies
Toutes les voies de transmission n’ont pas la même importance
Souffle de la personne
Animaux domestiques et rongeurs
Alimentation
Air
Matériau
Animaux vivants
Véhicules de transport, personnes, vêtements, bottes, mains
Nous avons un programme de biosécurité EXTERNE et un programme INTERNE FAIBLE
RISQUE
RISQUE ÉLEVÉ
Conseils
Les chaussures représentent un grand risque de propagation des bactéries, des virus (ex. grippe aviaire, peste porcine africaine, fièvre aphteuse, mastite environnementale...) et d’autres agents pathogènes de l’extérieur vers l’intérieur de l’exploitation, ainsi que de propagation d’un groupe d’animaux à un autre. Vous devez miser sur la biosécurité pour protéger votre cheptel et réduire l’utilisation d’antimicrobiens. Dans la mesure où les chaussures jouent un rôle majeur, il est conseillé d’utiliser des bottes différentes pour chaque zone afin d’empêcher la propagation des agents pathogènes d’un groupe à l’autre.
Garaje
Public road
Maison Garage Parking Sas d’hygiène Aliments Aliments Aliments Maison Garage Enfirmerie Sas d’hygiène Sas d’hygiène Entrée Entrée Entrée Parking Zone de chargement Zone lavage pour truies Truies Loges de mise bas Porcs d’engraissements Sas d’hygiène
Biosecurité

zone de chargement
Outils Zone de vêlage
Génisses
Maison Logement Réservoir à lait
Parking
Silo Silo
R&D et essais
Chaque botte Bekina est le fruit d’un long processus de développement, d’innovation et de tests de sécurité. Nous effectuons tous nos tests dans notre propre laboratoire d’essai, une installation moderne dans laquelle nous éprouvons constamment la performance, la qualité et la sécurité de nos bottes par rapport aux normes et standards internationaux les plus récents.
Dans notre laboratoire professionnel, nos bottes sont notamment testées pour vérifier:
Dans notre laboratoire professionnel, nos bottes sont notamment testées pour vérifier:






1 Leur caractère antistatique
2 Protection with a impact test
3 Leur résistance à l’usure, au moyen d’un test Martindale
4 Leur solidité, au moyen d’un test de compression


5 Leur élasticité et leur résistance à la déchirure
6 la protection S5 de la semelle, au moyen d’un test de perforation

7 l’usure de la semelle au moyen d’un test d’abrasion
8 la flexibilité de la semelle (flexing resistance) au moyen d’un test de flexion
1 5 6 7 8 2 3 4
La qualité de nos produits est contrôlée quotidiennement selon des tests standardisés au sein de notre laboratoire. Nous veillons ainsi à ce que tous nos produits répondent aux normes et standards les plus stricts. Pour garantir un produit de qualité constante, nous procédons à un contrôle rigoureux de nos approvisionnements en matières premières.


Nos bottes de sécurité sont conformes aux normes de sécurité européennes, britanniques, américaines, canadiennes et australiennes. Notre laboratoire est équipé du matériel nécessaire pour réaliser ces tests en toute indépendance. À cette fin, nous sommes audités chaque année par des organismes accrédités.

Le laboratoire est également équipé d’un matériel de pointe pour soutenir notre équipe de recherche et développement afin d’implémenter les dernières technologies et tendances du marché dans nos produits avec la plus grande durabilité.
Une garantie de sécurité mondialement reconnue
Bekina Boots travaille avec des instituts de test mondialement reconnus. Nos bottes respectent, de ce fait, les normes internationales en matière de sécurité. Nous pouvons donc vous garantir la meilleure protection pendant que vous portez nos bottes, même dans des conditions extrêmes.
Testées et approuvées par des professionnels
Nous faisons bien plus que réaliser des tests en laboratoire. Notre meilleure garantie en termes de sécurité et de durabilité, c’est vous. À cet égard, nous faisons tester tous nos nouveaux modèles pendant une longue période par un panel de professionnels. Nous développons une nouvelle paire de bottes destinées au secteur agricole ? Elles sont d’abord testées et approuvées par un panel d’agriculteurs. Nos bottes respectent ainsi non seulement les normes de sécurité internationales, mais aussi les exigences des personnes qui vont les porter chaque jour.
CARACTÉRISTIQUES
• Embout san métal et semelle antiperforation: rend la botte plus légère et plus chaude

• Chaussant large
• excellente adhésion même sur une surface mouillée et grasse - certifiée SRC
• semelle extérieure épaisse: isolation extra pour des pieds encore plus chauds



• Poignée d’echelle dans la semelle pour plus de sécurité
• Résistant aux huiles et graisses, au fumier et aux produits chimiques
• Résistant aux capures
Pointure:
couleurs:
Normes et certificats :
EU 37 - 48 | UK 4 - 13 | US 5 - 15
intérieures ergonomiques
+ Bekina Boots
Semelles
free
Avoir les pieds glacés est révolu avec les bottes StepliteX ThermoProtec. isolent thermiquement jusqu’à -40 °C.


Avantages des bottes basses:
• Idéales pour les mollets plus larges
• Idéales pour les personnes dont les jambes sont souvent trop chaudes
• Alternatives pour l’été
• Faciles à conduire des véhicules( tracteurs, camions)
• Combinaison parfait d’une chaussure de sécurité et d’une botte PU imperméable


+ Bekina Boots Semelles intérieures ergonomiques

CARACTÉRISTIQUES
• Botte ultralégère avec tirants latéraux pour faciliter le chaussage

• Sans ou avec fourrure
• Semelle extérieure antidérapante certifiée SRC

• Résistant aux capures
• Poignée d’echelle dans la semelle pour plus de sécurité
Pointure:
couleurs:
Normes et certificats :
Nouveau
Egalement disponible en noir
EU 36 - 49 | UK 3.5 - 14 | US 4 - 16
free
CARACTÉRISTIQUES
• Robuste et légère
• Chaussant large
• Excellente adhésion même sur une surface mouillée et grasse - certifiée SRC

• Poignée d’echelle dans la semelle pour plus de sécurité
• Ergot de déchaussement: facile à déchausser



• Résistant aux capures
• Résistant aux huiles et graisses, au fumier et aux produits chimiques
Semelles intérieures ergonomiques free
Pointure:
couleurs:
Normes et certificats :
EU 36 - 49 | UK 3.5 - 14 | US 4 - 16
+ Bekina Boots
Semelles intérieures
Assises plantaires ergonomiques


Résistance à l’usure –Traitement antimicrobien
EU 36 • 49
UK 3.5 • 14
US 4 • 16
Antidérapant –Anti-odeur
Contrôle climatique
Résistant à l’usure
Absorption des chocs
EU 36 • 48
UK 3.5 • 13
US 4 • 15
Chaussant ergonomique
Absorption des chocs
30°
Ref. B111
Ref. B101
Comment nettoyer vos bottes Bekina pour un résultat optimal et une durée de vie plus longue ?
1 Nettoyez régulièrement vos bottes avec de l’eau et un détergent approprié pour prolonger leur durée de vie.
2 L’intérieur des bottes doit également être nettoyé régulièrement à l’eau claire. Veillez à ce que l’intérieur des bottes soit bien sec avant de les enfiler.

3 Dosez correctement le détergent ou le nettoyant, comme indiqué sur l’emballage du produit.
4 Pour éviter tout dommage et toute découleuration, ne laissez pas les bottes tremper dans un détergent ou tout autre produit chimique.**
5 Une fois votre travail terminé, retirez votre surpantalon des bottes. Le matériau NEOTANE doit pouvoir sécher et respirer correctement.
* Utilisez un nettoyant ou un dégraissant neutre et un désinfectant adéquat. Adressez-vous à votre fournisseur de produits d’hygiène pour obtenir les bons produits. Avant d’utiliser des nettoyants et des désinfectants professionnels, lisez toujours l’étiquette ou la fiche technique.
25
Elles sont robustes et possèdent une très bonne adhérence. Je ne glisse ni ne tombe jamais. De plus, les bottes Thermolite IceShield gardent nos pieds au chaud pendant le lavage des poireaux. Mais le meilleur atout des bottes agricoles Bekina est leur tige plus large grâce à laquelle elles ne serrent pas les mollets
+ Bekina Boots Semelles intérieures ergonomiques

CARACTÉRISTIQUES
• Adhérence forte - certifié SRC

• semelle extérieure épaisse: isolation extra pour des pieds encore plus chauds


• Effet antichoc au talon
• Poignée d’echelle dans la semelle pour plus de sécurité
• Résistant aux huiles et graisses, au fumier et aux produits chimiques.
Pointure:
couleur:
Normes et certificats :
Ivo EU 39 - 47 | UK 6 - 12 | US 6 - 14
free

La botte de loisirs élégante, idéale pour toutes les activités extérieures.



CARACTÉRISTIQUES
• Avec allure
• Chaussant étroit
• Confort: légère et tige haute flexible
• Effet antichoc au talon
• Confortables pour se promener au travaille au jardin

+ Semelles intérieures
Pointure:

couleur:
J’aime chausser les bottes Litefield pour conduire mes cheveux en prairie. Ces bottes sont souples et légères.

Hilde De Ruyver

EU 36 - 47 | UK 3.5 - 12 | US 4 - 14
Bekina Boots
free

Sécurité couleur code du produit certificat















PAN1P/9180A ISO 20347:2012 PAN1P/1053A PAN3P/9180A ISO 20345:2011 PAN3P/1053A PAN3P/5353A PAN4P/9180A ISO 20345:2011 PAN4P/2080A PAN4P/8080A PAD1P/9180A ISO 20347:2012 XAN1P/9180A ISO 20347:2012 XAN3P/9180A ISO 20345:2011 XAN3P/1053A XAN3P/5353A XAN4P/9180A ISO 20345:2011 XAN4P/2080A XAN9P/8080A ISO 20345:2011 XMN1P/9180A ISO 20347:2012 XMN4P/9180A ISO 20345:2011 XRN4P/7080A ISO 20345:2011 XRN4P/8080A XFN4P/7080A ISO 20345:2011 XFN4P/8080A XAS9P/5562Y ISO 20345:2011 XAC8P/1053A ISO 20345:2011 XAC9P/9180A XAC9P/6253A ZAN4P/9180A ISO 20345:2011 SAN1P/9170A /
www.bekina-boots.com